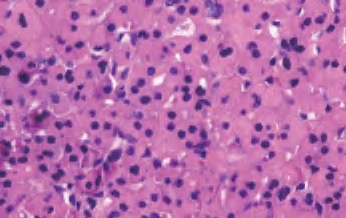

占甲状腺癌的20%~25%,更常见于女性,主要发生在50年龄段。临床表现:无症状的甲状腺内肿块。放射扫描中呈典型的冷结节。当伴有广泛转移时可出现声嘶、咽下困难和呼吸困难。
1.肉眼观察 通常有包膜,圆形、椭圆形实性肿瘤,直径超过1cm。切面灰白色,可侵占大部分甲状腺组织并侵出甲状腺包膜外,与周围组织粘连或侵入周围组织(图3-53)。
2.镜下 由滤泡细胞组成伴明显的纤维性包膜,缺乏乳头状癌典型的核特征。癌细胞显示不同的形态学变化,可排列成滤泡、实性巢索或小梁。然而,结构上和细胞的非典型特征都不能作为诊断恶性的可靠指证,必须见到肿瘤穿透包膜或(和)血管侵犯。根据侵袭程度分为:微小侵袭性滤泡癌[具有有限的包膜和(或)血管侵犯]和广泛侵袭性滤泡癌[广泛侵犯临近甲状腺组织和(或)血管](图3-54至图3-56)。

图3-53 甲状腺滤泡状癌大体

图3-54 甲状腺滤泡状腺癌

图3-55 甲状腺滤泡状腺癌,左侧可见血管侵犯

图3-56 甲状腺滤泡状腺癌
3.免疫组化呈甲状腺球蛋白(TG)、甲状腺转录因子-1(TTF-1)及细胞角蛋白(CK)阳性;某些滤泡癌CK19局灶阳性,与乳头状癌弥漫阳性不同。
4.组织学分型
(1)嗜酸细胞亚型:此型诊断时年龄较一般滤泡癌晚10年左右,淋巴结转移率达30%,并具有更高的颈部复发倾向。大体以独特的红褐色外观为特征,镜下可见全部或大部分(>75%)由嗜酸细胞构成。肿瘤从分化很好的滤泡结构到实体性或梁状结构,含较少或缺乏胶质,核浓染,有显著的嗜酸性核仁。胶质倾向于嗜碱性且常伴同心圆钙化,一些肿瘤可有透明细胞性改变,缺乏淋巴浆细胞浸润(图3-57、图3-58)。
(2)透明细胞亚型:主要由透明细胞组成,胞浆中含糖元、黏液、脂质或肿胀的线粒体。

图3-57 右侧为甲状腺滤泡状癌,嗜酸细胞亚型;左侧为正常甲状腺组织
图3-58 甲状腺滤泡状癌,嗜酸细胞亚型
5.鉴别诊断
(1)乳头状癌滤泡亚型:具有典型的乳头状癌核特征。
(2)嗜酸细胞性髓样癌:有巢状或岛状排列,癌细胞呈多角形,核呈圆形或椭圆形伴胡椒粉样染色质。嗜铬素A(CgA)、癌胚抗原(CEA)阳性,而TG阴性。
6.预后 微小侵袭性滤泡癌长期死亡率很低,而广泛侵袭性滤泡癌接近50%,且具有相当高的转移性。